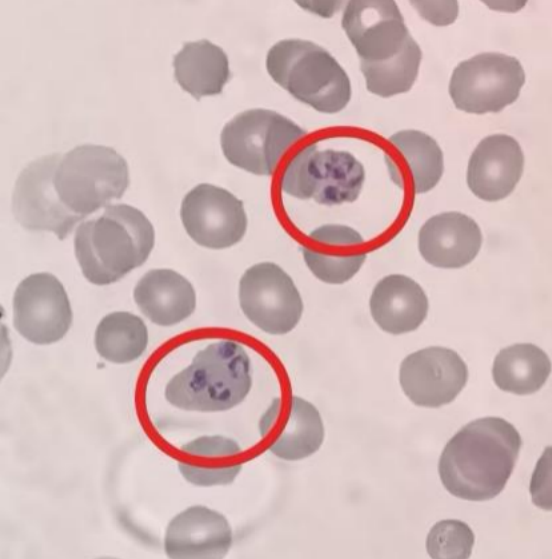

【全国疟疾日】这种病已在我国本土消除,但每年都有境外输入!一文了解“元凶”
每年的4月26日是“全国疟疾日”。或许有人会说,“疟疾不是已经被消除了吗?”
事实上,我国虽已在2021年获得世界卫生组织消除疟疾认证,
但每年依旧有大量的输入性疟疾病例,输入再传播的风险持续存在。
而这一切的幕后的真正元凶,正是一类不起眼却极具危害性的血液寄生虫——疟原虫。

疟原虫为单细胞真核生物,是引起疟疾的病原体。疟疾俗称“打摆子”“发疟子”,古代称“瘴气”,
主要是通过雌性按蚊叮咬或输入带疟原虫的血液而感染所引起的传染病,是一种可防可治的血液寄生虫病。
能感染人类的疟原虫有5种:恶性疟原虫、间日疟原虫、三日疟原虫、卵形疟原虫和诺氏疟原虫。
恶性疟原虫环状体期

在感染人类的五种疟原虫中,危害最大的两种疟原虫是恶性疟原虫与间日疟原虫,分别引起恶性疟和间日疟。
下面就让我们一起来看看它们在危害等级、临床表现、复发特性等方面有哪些区别:
守住无疟防线的核心就是防输入、断传播、早发现、快处置。
1.出境归来多留意。出境前往疟疾流行区的务工、旅游、商务和野外工作的人员为高风险人群,
回国后若出现发热、畏寒、乏力等症状,务必第一时间就医并主动报备旅居史。
2.防蚊灭蚊不松懈。做好个人防护至关重要,有蚊媒活动时,居家使用蚊帐、纱窗、蚊香及电蚊液等,
外出或野外活动时,穿浅色长袖衣裤,在暴露部位涂抹含避蚊胺的驱蚊剂。
3.早诊早治是关键。疟疾患者和疟原虫携带者是主要传染源,及时发现并规范治疗,防扩散。

消除疟疾不是终点,而是防控的新起点。
疟原虫虽然隐蔽,但是只要我们认清它的“真面目”,主动监测,及时发现,
做到早诊断早治疗,并科学防蚊灭蚊,就能杜绝这一元凶的危害。
守护健康,远离疟疾,共筑稳固公共卫生防线!/健康科普
- 上一篇:没有啦
- 下一篇:传染性强、后遗症严重!中疾控提醒:流脑进入高发季 2026/4/13
